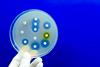
Antimicrobial,Susceptibility,Testing,In,Petri,Dish.,Antibiotic,Resistance,Of,Bacteria

All Antimicrobials articles
-
 News
NewsAI identifies 23 antiviral candidates for Bundibugyo Ebola strain
US researchers have deployed artificial intelligence and molecular docking software to identify 23 antiviral compounds with potential activity against Bundibugyo Ebolavirus, as the rare strain continues to spread in the Democratic Republic of Congo with a fatality rate approaching 40 percent.
-
 Article
ArticleWhen antibiotics are not enough: the case for immune-engaging therapies
As antimicrobial resistance grows and patient populations become more complex, the limitations of antibiotics are becoming harder to ignore. Dr Helen Bright, CSO at Centauri Therapeutics, discusses a new approach that targets both the pathogen and the host.
-
 News
NewsAI system transforms weak antibiotics into powerful treatments
University of Pennsylvania researchers have developed ApexGO, an AI system that refines imperfect antibiotic candidates through calculated modifications rather than database screening.
-
 News
NewsTwo antimicrobials show efficacy against drug-resistant pneumonia pathogen
A preclinical study from Osaka Metropolitan University demonstrates that levofloxacin and cefiderocol both show therapeutic potential against severe hemorrhagic pneumonia caused by the multidrug-resistant pathogen Stenotrophomonas maltophilia.
-
 Article
ArticleFrom leaderboards to lab notebooks: AI designs reach preclinical testing
For years, AI drug discovery has been judged on benchmark performance. Now, a set of studies shows what happens when those designs are made and tested in preclinical settings.
-
 News
NewsNew strategy targets antibiotic resistance in cystic fibrosis
Researchers at the University of Texas at Austin have demonstrated that targeting a bacterial protein-folding pathway can disable antimicrobial resistance and cross-protection, restoring antibiotic susceptibility in preclinical models of cystic fibrosis infection.
-
 News
NewsHuman antimicrobial peptide dermcidin shows antiviral activity against influenza
Researchers at Fisabio Foundation have discovered that dermcidin, an antimicrobial peptide naturally present in human sweat, exhibits antiviral activity against influenza by binding to viral haemagglutinin and preventing cell fusion, opening new possibilities for innate immunity-based therapeutics.
-
 News
NewsCamel-derived peptides target multidrug bacteria
Researchers at Sultan Qaboos University have identified three antimicrobial peptides from dromedary camels that demonstrate potent activity against multidrug-resistant bacteria.
-
 News
NewsScientists develop synthetic bacteriophages to fight drug-resistant bacteria
Scientists have developed the first fully synthetic method for building and reprogramming bacteriophages, offering a faster and safer route to designing virus-based treatments for drug-resistant bacteria.
-
 News
NewsNew study identifies genetic weakness in deadly Candida auris fungus
Scientists at the University of Exeter have discovered a genetic process in the deadly hospital fungus Candida auris, which could help to develop new treatments.
-
 News
NewsNew mRNA therapy targets drug-resistant pneumonia
A new mRNA therapy that prompts the body to produce bacteria-killing ‘peptibodies’ has shown early success in preclinical models, offering a potential new tool in the fight against antibiotic-resistant pneumonia.
-
 Article
ArticleRVX-001: a universal vaccine to tackle antimicrobial resistance
Drug-resistant infections are on the rise, endangering global health. Neil Murray from ReNewVax explains how the company’s universal pneumococcal vaccine, RVX-001, could reduce antibiotic use and help curb antimicrobial resistance.
-
 News
NewsNew antibiotic discovery could help tackle antimicrobial resistance
Scientists have discovered a powerful new antibiotic hidden within the compound pre-methylenomycin C lactone, which shows real effectiveness against drug-resistant infections such as MRSA and VRE.
-
 News
NewsHow medications in waterways are encouraging antibiotic resistance
New research has discovered that mixtures of everyday medications in the environment can promote antibiotic resistance, offering new insights that could influence future drug discovery and environmental policy.
-
 News
NewsComFB protein discovery could help fight antibiotic resistance
Scientists have discovered a new family of bacterial proteins – called ComFB – that regulate both movement and DNA uptake – suggesting potential new methods to combat pathogenic infections.
-
 News
NewsNanoparticles turn vinegar into powerful antimicrobial treatment
Scientists have supercharged vinegar’s antibacterial properties by adding carbon and cobalt nanoparticles – creating a powerful, non-toxic treatment that could help combat drug-resistant infections and speed up wound healing.
-
 News
NewsNovltex: new antibiotic targets antimicrobial resistance
Scientists at the University of Liverpool have discovered Novltex, a new class of antibiotics that shows potent activity against deadly multidrug-resistant bacteria such as MRSA.
-
News
NewsAI designs new antibiotics to take on drug-resistant superbugs
Penn engineers have built an AI model that creates new antibiotics – and early tests show some work as well as existing approved drugs.
-
 News
NewsHow FtsZ and ZapA proteins drive bacterial cell division
Japanese researchers have discovered how the bacterial proteins FtsZ and ZapA work together to drive cell division – a discovery that could guide the development of new antibacterial treatments.
-
 News
NewsDual-action therapy clears MDR bacteria in preclinical models
Centauri Therapeutics has published data showing that CTX-09’s ability effectively clears drug-resistant Gram-negative bacteria through a novel dual mechanism, marking a promising development for new infection therapies.



